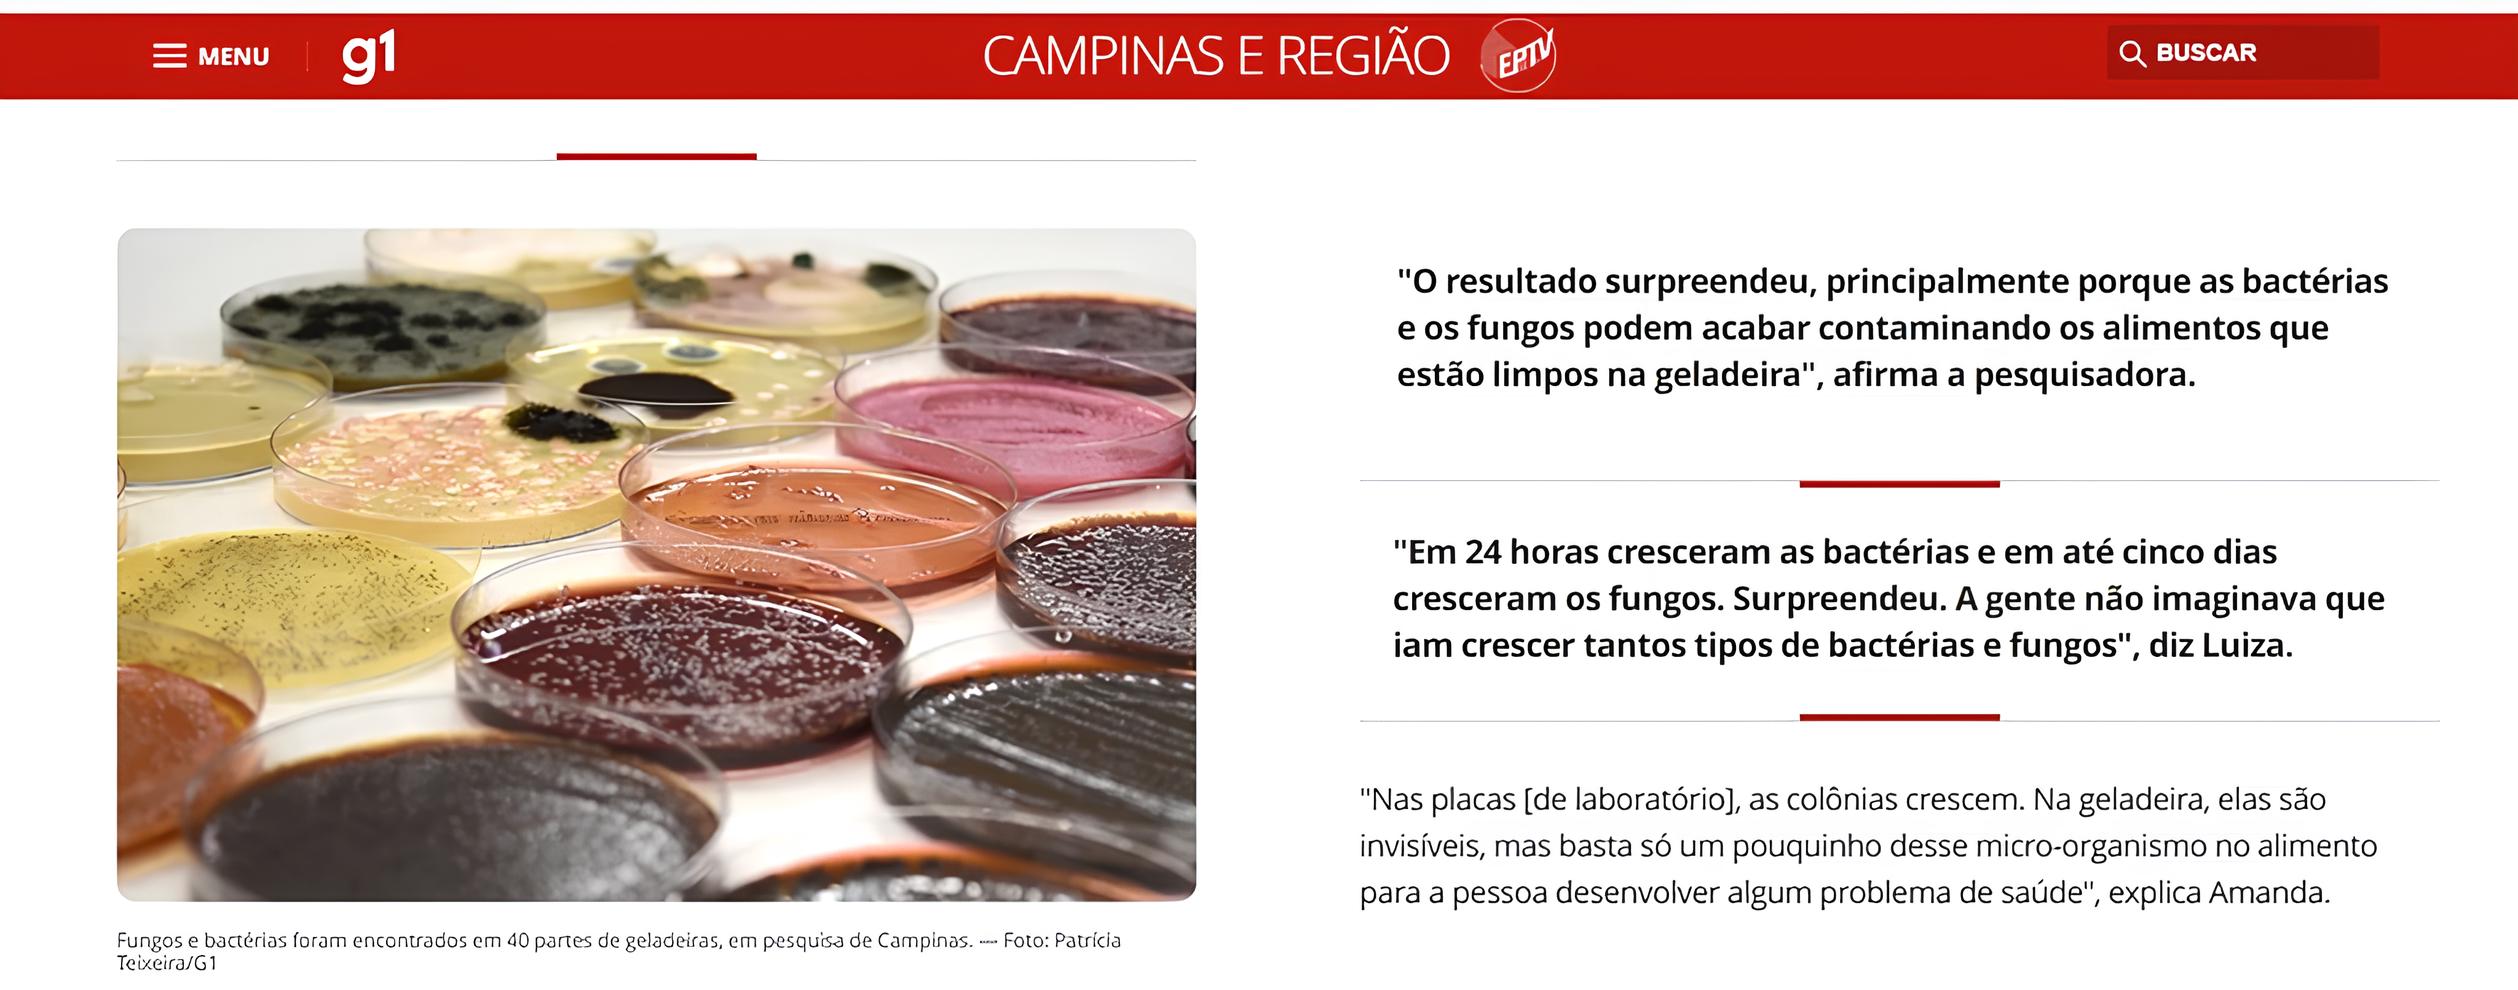
66f599edd3f92.jpg

Ref.:
3562689650
|
Disponibilidade:
Imediata
Seladora a Vácuo para Alimentos - Vacuum Sealer
R$ 189,90